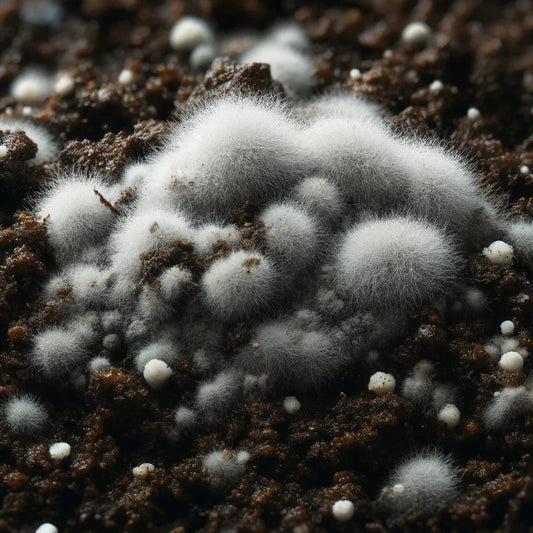
cobweb mold in monotub mushroom growing

Gro Magik Blog
Cobweb Mold In Monotub Mushroom Growing
Struggling with cobweb mold in your monotub? Learn how to identify, prevent, and treat cobweb mold to keep your mushroom grow healthy and contamination-free.
Cobweb Mold In Monotub Mushroom Growing
Struggling with cobweb mold in your monotub? Learn how to identify, prevent, and treat cobweb mold to keep your mushroom grow healthy and contamination-free.

Do Mushrooms Need Light To Grow?
Mushrooms, the fruiting bodies of fungi, have fascinated cultivators and chefs alike with their diverse flavors and textures. Unlike plants, mushrooms do not rely on photosynthesis, leading to common misconceptions...
Do Mushrooms Need Light To Grow?
Mushrooms, the fruiting bodies of fungi, have fascinated cultivators and chefs alike with their diverse flavors and textures. Unlike plants, mushrooms do not rely on photosynthesis, leading to common misconceptions...

What is Microdosing? Legality, Protocols, & Ben...
Wondering what microdosing is? Explore the legality, protocols, and benefits of microdosing mushrooms for mental clarity, creativity, and overall well-being.
What is Microdosing? Legality, Protocols, & Ben...
Wondering what microdosing is? Explore the legality, protocols, and benefits of microdosing mushrooms for mental clarity, creativity, and overall well-being.

Laminar Flow Hoods, How To Use & What To Buy
Learn how to use laminar flow hoods for mushroom cultivation. Discover what to look for when buying one and how it can improve your sterile environment.
Laminar Flow Hoods, How To Use & What To Buy
Learn how to use laminar flow hoods for mushroom cultivation. Discover what to look for when buying one and how it can improve your sterile environment.

The Essential Guide to Using Still Air Boxes
Master the use of still air boxes with this essential guide. Learn how to create a sterile environment for mushroom cultivation and avoid contamination effectively.
The Essential Guide to Using Still Air Boxes
Master the use of still air boxes with this essential guide. Learn how to create a sterile environment for mushroom cultivation and avoid contamination effectively.

Sterilization & Contamination Prevention Techni...
The allure of growing mushrooms lies not only in their unique flavors and nutritional benefits but also in their ability to thrive in a variety of environments, from rural farms...
Sterilization & Contamination Prevention Techni...
The allure of growing mushrooms lies not only in their unique flavors and nutritional benefits but also in their ability to thrive in a variety of environments, from rural farms...
